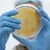

Save up to 20% on your first order
Apply HELLO20
Apply HELLO20
Description: A scientist moves a plastic plate with cells on a microscope, studies microbes in a microbiological plate under a microscope. Working with a microscope in the laboratory.
Working With A Microscope In The Laboratory. Video
Pripetty's Artist Page
Item ID: 201555470
Editorial Usage
Individual License Included
|
Upgrade
This item is for editorial usage only. Need commercial use?
To discuss commercial use options, please send your request to our .
Related Tags
Video Categories
- 360 VR
- Aerials
- Agriculture
- Animals
- Animation
- Backgrounds
- Business
- Cities & Urban
- Crime & Law
- Education
- Elements & Objects
- Fantasy & Sci-fi
- Fashion & Beauty
- Food & Drinks
- Green Screen
- Holidays
- Industry
- Medical
- Military
- Nature
- People & Lifestyle
- Politics
- Culture & Religion
- Science
- Slow Motion
- Space
- Sports
- Technology
- Timelapse
- Transportation
- VFX
- Vintage & Archival